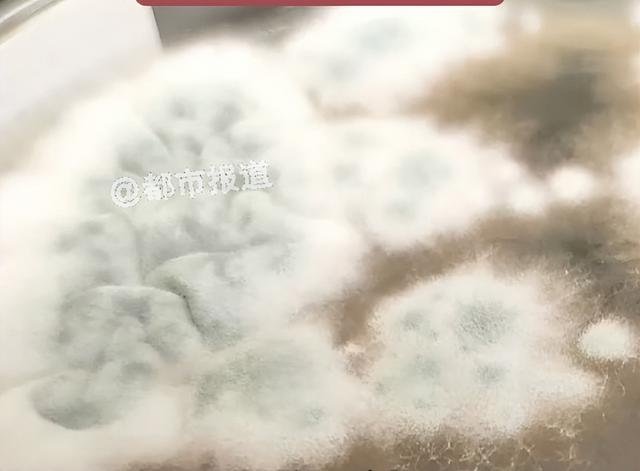

近日
有媒体报道
河南一名6岁女童持续高烧达17天
出现意识模糊症状后被送往郑州治疗
医生在检查中惊讶地发现
孩子的脑部竟然出现了多个空洞
若再晚几天可能就会导致脑组织被完全破坏

通过抽取脑内积液进行检测
最终确认病因是烟曲霉菌感染
专家表示
烟曲霉菌多存在于潮湿环境中
孩子在接触这些环境后
霉菌通过呼吸道进入血液
最终侵入大脑
因霉菌引发的疾病
此前也曾引起关注
▽
上海一位周先生
长期感到四肢疼痛、头晕
严重影响日常生活
经检查被诊断为类风湿和偏头痛
医生建议他检查家中环境
当他移开衣橱后
发现窗外堆积着建筑与生活垃圾
房间角落及衣柜内部均有明显霉斑
上海一男子关节疼痛、头晕恶心,得了怪病?医生:家里有问题;挪开衣橱大吃一惊......
医生提醒
日常生活中应保持室内通风
一旦发现发霉现象
要及时清理
避免对健康造成影响
新民晚报(xmwb1929)综合都市报道、大象新闻、新闻坊
编辑:施雨
编审:陈莉